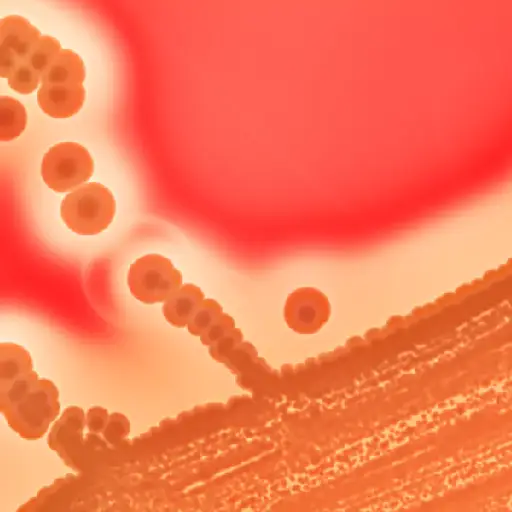

近距离湿疹:神话和不寻常的并发症
在3000万美国人与湿疹一起生活,但许多患有湿疹的人可能没有意识到与湿疹有关的一些意外但往往是严重的并发症。我们来看看一些仍然存在的误区,一些不太为人所知的与这种皮肤状况有关的并发症,以及一些可以避免这些问题的方法。


误区二:疫苗会导致湿疹
不,接种疫苗不会引起湿疹吗皮肤科医生鼓励患有湿疹的人接种疫苗。然而,对鸡蛋有严重过敏反应的湿疹患者应该向医生咨询两种疫苗的替代方案;麻疹、腮腺炎和风疹(MMR)疫苗和流感疫苗。患有湿疹的人也应避免接触活天花疫苗。

湿疹、葡萄球菌和流感疫苗
一些研究发现,皮肤上有金黄色葡萄球菌的湿疹患者有减少免疫反应接种流感疫苗研究表明,当疫苗被注射到皮肤中时,他们的免疫系统并没有完全受益。然而,当疫苗被注射到肌肉中时,它同样有效。

活天花疫苗可导致严重感染
患有湿疹的人——或者曾经患过湿疹(即使是几年前)——应该避免现场天花疫苗并在接种后30天内避免与接种过疫苗的人进行皮肤接触。对大多数人来说,这不是问题,因为天花在几十年前就被消灭了,疫苗也没有给普通大众。但是一些在军队服役的人和一些可能接触过天花的研究人员和实验室工作人员可能接种了天花疫苗。

罕见并发症:湿疹疫苗
对于患有湿疹的人来说,活天花疫苗会导致一种罕见但严重的感染牛痘性湿疹(电动汽车)。这种感染是由于天花疫苗中的活病毒繁殖并传播到接种部位以外,导致全身出现结痂性皮疹,以及发热和水肿(或肿胀)。这可能会危及生命。正因为如此,活天花疫苗不应该给与有湿疹史的人有过密切接触的人接种。
谬论:湿疹是会传染的
不,你不能把湿疹传染给别人。然而,湿疹和它引起的鳞状皮疹会损害你的皮肤屏障,使你更容易发生皮肤感染。这些感染可能具有传染性——尤其是对那些有湿疹、其他皮肤状况或免疫系统受损的人。
疱疹性湿疹
疱疹性湿疹唇疱疹是一种通常由单纯疱疹病毒或“口腔疱疹”引起的感染——这种病毒会导致唇疱疹出现在口腔周围和内部,但也会出现在身体的其他地方。患有湿疹和其他炎症性皮肤疾病的人更容易受到这种感染,这种感染会导致一簇簇红色、紫色或黑色的小水泡,并且瘙痒和疼痛。通常伴有高烧、腺体肿胀和全身不适。这种感染可能非常严重,特别是当它扩散到大面积皮肤时。
严重湿疹儿童生长受阻的可能原因
一种可能是长期的压力和睡眠障碍——由持续的抓挠引起——会损害一些儿童的正常生长激素周期。另一种可能是,患有湿疹的儿童经常有食物过敏,这可能会限制他们吃什么食物,影响他们的营养水平。

局部类固醇治疗湿疹可能导致生长迟缓
另一个问题是糖皮质激素,常用于治疗湿疹,可延迟或减缓一些严重湿疹儿童的生长。长期使用皮质类固醇治疗的年轻患者(通常局部使用,但有时口服)应密切监测其生长情况。
蕾切尔·佐恩是一位母亲、妻子和自由撰稿人,她努力寻找最佳的方法来平衡这一切,并保持幽默感。她曾是一名报社记者,对写与健康、健康和人体有关的所有事情都有浓厚的兴趣。她喜欢写各种健康话题,包括湿疹、不同类型的癌症和季节性过敏等皮肤状况。